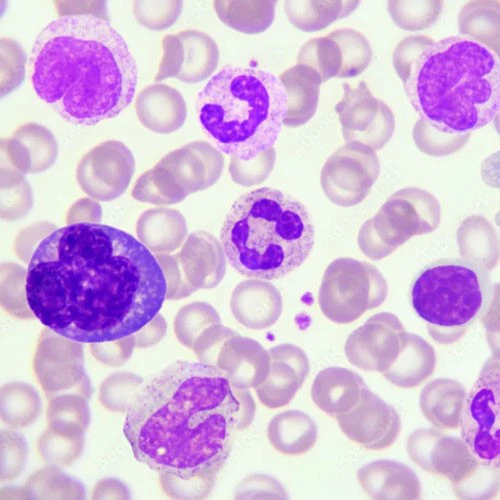
Slu-PP-332 buy | Shaanxi BLOOM Tech Co., Ltd Slu-PP-332 buy | Shaanxi BLOOM Tech Co., Ltd

Shaanxi BLOOM Tech Co., Ltd. is one of the most experienced manufacturers and suppliers of SLU-PP-332 Peptide in China. Welcome to wholesale bulk high quality SLU-PP-332 Peptide for sale here from our factory. Good service and reasonable price are available.
Slu-PP-332 Peptide is a small molecule compound with the molecular formula C18H14N2O2 and a molecular weight of 290.32. Its structure consists of naphthalene ring, benzene ring, and hydrazide groups, and this unique molecular configuration endows it with the ability to bind estrogen related receptors (ERRs) with high affinity. As a pan ERR agonist, it has EC ₅₀ values of 98 nM, 230 nM, and 430 nM for ERR α, ERR β, and ERR γ, respectively, with the strongest activation effect on ERR α. This characteristic makes it an ideal tool molecule for studying the function and metabolic regulation of ERRs.
At the same time, our company not only provides SLU-PP-332 pure powder, but also offers tablets, injections, and capsules. If needed, please feel free to contact us at any time.
Our product



Recently, due to increased orders for SLU-PP-332 Capsules, we have stocked up on a large quantity of inventory across multiple specifications. So we update the retail unit price for small qty, pls check:
The spot price is 20% off the original price!!!
May I know how many mcg size in how many PCS do you want to order?
SLU-PP-332 Capsules
| Price list on sale for in stock product | |
| 250mcg | 500mcg |
|
500 PCS, $200 USD 1,000 PCS, $256 USD 10,000 PCS, $800 USD |
500 PCS, $240 USD 1,000 PCS, $312 USD 10,000 PCS, $880 USD |
| Price List of Slupp-332, CAS 303760-60-3 | |||||||
| Category | Specification (Content/PCS) |
Qty | Unit Price (EXW,USD$/Unit) |
Total Price (EXW,USD$) |
Package | Unit | Remark |
| Capsule | 250mcg | 500 1,000 10,000 |
$0.50/PCS $0.32/PCS $0.10/PCS |
$250 $320 $1,000 |
Aluminum foil bag 50 PSC/Bag or negotiable |
PCS |
Reamrk:
|
| 500mcg | 500 1,000 10,000 |
$0.60/PCS $0.39/PCS $0.11/PCS |
$300 $390 $1,100 |
PCS | |||
| 1mg | 500 1,000 10,000 |
$0.72/PCS $0.47/PCS $0.13/PCS |
$360 $470 $1,300 |
PCS | |||
| 5mg | 500 1,000 10,000 |
$0.92/PCS $0.58/PCS $0.20/PCS |
$460 $580 $2,000 |
PCS | |||
| 10mg | 500 1,000 10,000 |
$1.12/PCS $0.70/PCS $0.24/PCS |
$560 $700 $2,400 |
PCS | |||
| 20mg | 500 1,000 10,000 |
$1.36/PCS $0.92/PCS $0.38/PCS |
$680 $920 $3,800 |
PCS | |||
| Injection | 5mg/vial | 1 | $195/Box | $195 | 10 vials/Box | Box | MOQ 1 Box |
| API (Pure powder) |
HPLC>99.0% HNMR |
10 100 1000 |
$30.0/Gram $12.0/Gram $6.8/Gram |
$300 $1,200 $6,800 |
(1)Internal: PE bag+Al foil bag (2)External: Paper box |
Gram | MOQ 10 grams |



SLU-PP-332 COA



Treatment with Slu-PP-332 (0-5 μ M, 24 hours) significantly increased the protein expression of mitochondrial respiratory chain complex I (NDUFB8) and complex V (ATP5A), while inducing upregulation of mitochondrial biogenic marker genes PGC-1 α and TFAM. After activating ERR γ, the expression of fatty acid oxidation related genes CPT1A and ACADL increases, and lipid accumulation decreases. After 28 days of continuous intraperitoneal injection of it (50 mg/kg, twice daily) into obese mice, body weight decreased by 12% -15%, fat mass decreased by 22%, and no hepatotoxicity or nephrotoxicity was observed; After administration to mice with heart failure, myocardial cell crest density increased by 40%, fatty acid oxidase activity increased by 2.1 times, and exercise endurance significantly improved; Meanwhile, in 24 month old mice, it can reverse muscle atrophy, increase muscle fiber cross-sectional area by 15% -20%, and delay age-related metabolic decline.

Mandatory intervention of Slu-PP-332: smoothing the waves of metabolism
In modern society with a high incidence of metabolic diseases, traditional intervention methods such as exercise and dietary control are effective, but due to factors such as patient compliance and physical conditions, it is difficult to achieve comprehensive coverage. The product, with its unique metabolic regulation mechanism, breaks the vicious circle of metabolic imbalance through "mandatory intervention", and opens up a new path for the treatment of obesity, diabetes, heart failure and other metabolic related diseases.
Mechanism of action of Slu-PP-332: activation of ERRs, reconstruction of metabolic network
Slu-PP-332 Peptide is a pan estrogen related receptor (ERR) agonist that can simultaneously activate three subtypes of ERR α, ERR β, and ERR γ, with the highest affinity for ERR α (EC ₅₀=98 nM). ERRs, as the core regulatory factors of cellular energy metabolism, are widely distributed in high energy consuming organs such as the heart, liver, and skeletal muscle. They maintain energy supply and demand balance by regulating key metabolic pathways such as mitochondrial biosynthesis, fatty acid oxidation (FAO), and oxidative phosphorylation (OXPHOS).
Precise regulation of energy metabolism "switch"
It functions as a molecular mimic of exercise, exerting its beneficial metabolic effects primarily through the activation of ERR signaling pathways. It directly modulates core energy switches, shifting systemic metabolism toward enhanced catabolism and efficient energy utilization.
Enhanced fatty acid oxidation: It strongly promotes the breakdown and combustion of fat stores. In preclinical models using diet-induced obese mice, oral administration of it significantly increased hepatic and muscular fatty acid oxidation rates by 25–50%. The body preferentially switches to using fat as the primary fuel source, reducing excessive reliance on glucose consumption, improving peripheral insulin sensitivity, and lowering fasting blood glucose and insulin levels.
Mitochondrial function optimization: The compound strongly stimulates mitochondrial biogenesis by upregulating key transcription factors, including mitochondrial transcription factor A (TFAM). This leads to a measurable increase in mitochondrial density (approximately 25%) and substantial improvements in ATP production efficiency (around 30%), markedly enhancing cellular respiratory capacity and overall oxidative metabolism.
Conversion of muscle fiber types: It induces a phenotypic shift in skeletal muscle fibers, promoting the formation and maintenance of oxidative type I muscle fibers. The proportion of these fatigue-resistant, high-endurance fibers increases by 35–40%. In functional tests, treated mice demonstrate significantly improved exercise performance, with prolonged running time by up to 70% and increased running distance by 45%, reflecting enhanced endurance capacity similar to chronic exercise adaptation.
Systematic reshaping of metabolic pathways
Transcriptomic and gene expression analyses reveal that Slu-PP-332 Peptide orchestrates a broad and coordinated metabolic program. It strongly upregulates a panel of genes critical for fatty acid metabolism, including CPT1 and MCAD, which control rate-limiting steps in fat oxidation. It also enhances the expression of master regulators of mitochondrial function, such as PGC-1α and NRF1, as well as exercise-responsive adaptive genes including Ddit4. Concurrently, Slu-PP-332 suppresses the expression of pro-inflammatory cytokines such as IL-6 and TNF-α, thereby reducing chronic low-grade inflammation, a key driver of insulin resistance and metabolic deterioration.

This multi-target, multi-pathway regulatory profile enables it to stabilize and smooth extreme fluctuations in metabolism at the molecular level. Instead of merely alleviating individual symptoms, it achieves holistic restoration of metabolic homeostasis, making it a highly promising intervention for a spectrum of interrelated metabolic disorders.
Mandatory Intervention and the Restoration of Metabolic Homeostasis
The term "mandatory intervention" highlights the unique pharmacological advantage of the product: it actively drives metabolic improvement without relying entirely on voluntary behavior changes. In patients with long-term metabolic disorders, the internal regulatory system often becomes desensitized or dysregulated, resulting in persistent insulin resistance, fat accumulation, energy waste, and low-grade chronic inflammation. In such a state, simple lifestyle adjustments are often insufficient to reverse the pathological process.

It acts directly on the upstream regulatory nodes of energy metabolism, forcibly reactivating the blocked ERR signaling pathway, restarting efficient mitochondrial function, and restoring the body's natural ability to burn fat and maintain glucose balance. Unlike traditional hypoglycemic or lipid-lowering drugs that only act on a single indicator, it does not temporarily cover up symptoms, but stabilizes the entire metabolic system from the source, smoothing sharp fluctuations in blood glucose, lipid, and energy supply.
This kind of mandatory but mild regulation helps the body gradually break away from the pathological vicious cycle, rebuild a stable and healthy metabolic steady state, and provides a reliable pharmacological basis for the long-term management of obesity, type 2 diabetes, metabolic syndrome, and metabolic cardiomyopathy.
Classification and specific manifestations of adverse reactions
Slu-PP-332 Peptide, as a novel peptide, was initially discovered to have potential roles in regulating physiological functions and participating in specific pathological processes of diseases. Therefore, it attracted the attention of researchers and began to enter the laboratory research and some early clinical trials. However, as research progresses, the potential adverse reactions it may cause gradually become apparent. These adverse reactions not only affect the clinical application prospects of the peptide substance, but also directly impact drug safety. Therefore, a systematic and comprehensive study and analysis of its adverse reactions has important theoretical significance and practical application value.
Local adverse reactions
Local adverse reactions are a type of reaction that is more likely to occur during the administration of it, mainly concentrated in the administration site and surrounding tissues. They are usually related to the stimulation of local tissues by the drug, improper administration methods, or individual differences in local sensitivity to the drug.
Red swelling and pain at the injection site
In experimental studies and early clinical observations using it for injection administration, redness, swelling, and pain at the injection site were the most common local adverse reactions. Research data shows that approximately 30% -40% of individuals in experimental animals (such as mice and rats) and a small number of volunteers who receive injections of this peptide exhibit varying degrees of redness and swelling at the injection site. The range of redness and swelling is usually small, with a diameter of 1-3 centimeters and a color of light red or pink. It usually appears within a few hours after administration, and some individuals' redness and swelling symptoms can disappear on their own within 1-2 days. However, there are also a few individuals whose redness and swelling lasts for a long time, up to 3-5 days.
Pain symptoms often accompany redness and swelling, and the degree of pain varies from person to person.

Some individuals may only experience mild pain or swelling, which does not affect normal activities; However, a small number of sensitive individuals may experience more obvious pain, and even the pain intensifies when touching or moving the surrounding tissues of the injection site, causing certain interference in daily life.Further research has found that this redness, swelling, and pain response may be due to the stimulation of local capillaries at the injection site by it, leading to capillary dilation and congestion, as well as the release of local inflammatory mediators (such as histamine, prostaglandins, etc.), thereby causing local tissue inflammation.

Local skin itching and rash
In addition to redness, swelling, and pain, local skin itching and rash are also possible local adverse reactions that it may cause. In related studies, about 15% -20% of experimental subjects experienced skin itching symptoms after administration, with itching mainly concentrated around the injection site. Some individuals may scratch due to itching, leading to skin damage and increasing the risk of infection. The manifestations of rash are diverse, commonly including papules, urticaria, etc. Spotted papules are mostly scattered red small papules with a diameter of about 1-2 millimeters, and some papules may merge into patches; Urticaria presents as a wheal like rash, with a light red or pale white color, varying in size and irregular shape. It usually appears within a few hours and can self resolve within a few hours to days, but is prone to recurrence. After analysis, this type of skin reaction may be a manifestation of allergic reactions.
Slu-PP-332 Peptide, as an exogenous substance, may be recognized by the immune system as a "foreign body" after entering the body, triggering an immune response and releasing allergic mediators, leading to symptoms such as skin itching and rash.
Localized tissue hardening and necrosis (rare)
In rare cases, it may cause severe local adverse reactions such as local tissue hardening and necrosis. In current research cases, only a few experimental animals have experienced such situations. Local tissue induration is usually manifested as a hard mass with unclear boundaries at the injection site, which may be accompanied by pain when pressed. The resolution time of induration is relatively long, and some may take several weeks or even months. However, local tissue necrosis is even rarer. Once it occurs, it can lead to ischemia and hypoxia in the injection site tissue, resulting in necrosis. This is manifested as blackening of the local skin color, tissue ulceration, pus discharge, etc., which seriously affects the local tissue function. Moreover, the treatment is difficult and often requires debridement, and may even leave scars.

The mechanism of this serious local adverse reaction may be due to the high concentration of the drug in the local tissue, which has a toxic effect on tissue cells, destroys cell structure and function, leads to cell death, and subsequently causes tissue hardening and necrosis; It may also be related to an individual's extreme sensitivity to drugs, leading to strong local inflammatory reactions and tissue damage.

The digestive system is one of the commonly affected systems when it causes systemic adverse reactions, mainly manifested as nausea, vomiting, diarrhea, abdominal pain, and other symptoms. In relevant clinical and animal experiments, about 25% -30% of the subjects showed varying degrees of digestive system symptoms. Nausea symptoms usually appear within a few hours after administration, manifested as discomfort and nausea in the upper abdomen. Some individuals may experience vomiting, which is mostly stomach contents. The frequency of vomiting varies, ranging from 1-2 times to several times. The incidence of diarrhea symptoms is relatively low, with nausea and vomiting accounting for about 15% -20%.
It is characterized by an increase in the frequency of bowel movements, changes in stool characteristics, and mostly watery or pasty stools. Some individuals may also experience abdominal pain, which is mostly located around the navel or lower abdomen. The nature of the pain is often paroxysmal colic or dull pain, and the severity of the pain varies. Severe cases may lead to complications such as severe abdominal pain, frequent diarrhea, dehydration, and electrolyte imbalance.
Neurological adverse reactions
Neurological adverse reactions are also one of the systemic adverse reactions that Slu-PP-332 Peptide may cause. Although the incidence is relatively low, the impact on the body cannot be ignored, mainly manifested as symptoms such as headache, dizziness, fatigue, and drowsiness. In rare cases, psychological symptoms such as insomnia, anxiety, and restlessness may occur. The incidence of headache symptoms in the experimental subjects is about 10% -15%. The headache site is mostly bilateral temples or forehead, and the nature of the pain is mostly swelling pain, dull pain or pulsating pain. The severity of the pain varies. Some individuals' headache symptoms may be relieved after rest, while a few individuals' headaches may last for a long time, affecting normal work and life.

The incidence of dizziness symptoms is similar to that of headaches, about 10% -12%, manifested as head heaviness, visual rotation or unstable standing, especially when changing positions (such as standing up from a sitting or lying position), the symptoms may be more obvious, and severe cases may cause falls due to dizziness, resulting in accidental injury.
FAQ
Is it hormonal?
+
-
It is a compound which is a potent but non-selective estrogen-related receptor (ERR) agonist, acting most strongly at ERRα with an EC50 of 98 nM. It was found to counteract metabolic syndrome in mice, suggesting a possible role for compounds from this class as medications for the treatment of obesity.
How does the product affect the heart?
+
-
Importantly, it was very effective in improving heart function in a model of heart failure that was coupled to its ability to enhance fatty acid oxidation and mitochondrial metabolism,38 validating its function as an ERR agonist.
Hot Tags: SLU-PP-332 Peptide, suppliers, manufacturers, factory, wholesale, buy, price, bulk, for sale, Cosmetic, DERMORPHIN, dermorphin in humans, dermorphin peptide, Melanotan ii powder








